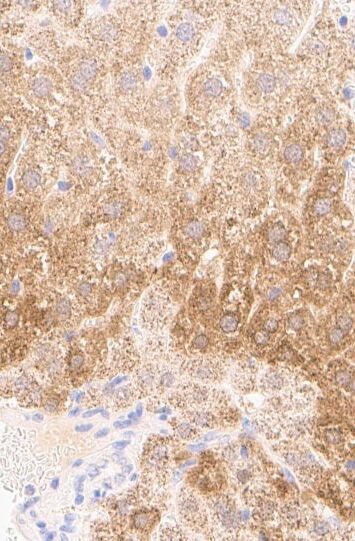

| Immunogen | This antibody was developed against a recombinant protein corresponding to the amino acids: QHAKSVLPKSIYDYYRSGANDEETLADNIAAFSRWKLYPRMLRNVAETDLSTSVLGQRVSMPICVGATAMQRMAHVDGELATVR |
| Isotype | IgG |
| Clonality | Polyclonal |
| Host | Rabbit |
| Gene | HAO1 |
| Purity | Affinity purified |
| Innovator's Reward | Test in a species/application not listed above to receive a full credit towards a future purchase. |
| Dilutions |
|
||
| Application Notes | For IHC-Paraffin, HIER pH 6 retrieval is recommended. |
||
| Control Peptide |
|
||
| Reviewed Applications |
|
||
| Publications |
|
| Storage | Store at 4C short term. Aliquot and store at -20C long term. Avoid freeze-thaw cycles. |
| Buffer | PBS (pH 7.2) and 40% Glycerol |
| Preservative | 0.02% Sodium Azide |
| Purity | Affinity purified |
| Publication using NBP2-14080 | Applications | Species |
|---|---|---|
| Kampf C, Mardinoglu A, Fagerberg L et al. The human liver-specific proteome defined by transcriptomics and antibody-based profiling. FASEB J 2014-07-01 [PMID: 24648543] |
| Images | Ratings | Applications | Species | Date | Details | ||||||||||
|---|---|---|---|---|---|---|---|---|---|---|---|---|---|---|---|

Enlarge |
reviewed by:
Vojtech Gabriel |
IHC-P | Turtle | 05/11/2022 |
Summary
|
||||||||||

Enlarge |
reviewed by:
Hannah Wickham |
IHC-P | Canine | 03/11/2022 |
Summary
Comments
|
||||||||||
Enlarge |
reviewed by:
Faye Doherty |
IHC-P | Mouse | 07/01/2019 |
Summary
Comments
|
Secondary Antibodies |
Isotype Controls |
Research Areas for Hydroxyacid Oxidase-1/HAO-1 Antibody (NBP2-14080)Find related products by research area.
|
The concentration calculator allows you to quickly calculate the volume, mass or concentration of your vial. Simply enter your mass, volume, or concentration values for your reagent and the calculator will determine the rest.
5 | |
4 | |
3 | |
2 | |
1 |
| Vojtech Gabriel 05/11/2022 |
||
| Application: | IHC-P | |
| Species: | Turtle |
| Hannah Wickham 03/11/2022 |
||
| Application: | IHC-P | |
| Species: | Canine |
| Faye Doherty 07/01/2019 |
||
| Application: | IHC-P | |
| Species: | Mouse |
| Gene Symbol | HAO1 |